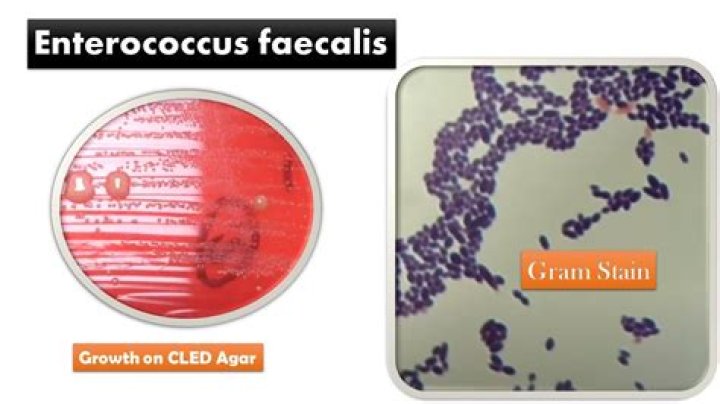
Cover

Is Enterococcus sensitive to ciprofloxacin?
Nevertheless, recent studies have indicated the presence of Enterococcus faecalis strains sensitive to vancomycin and ciprofloxacin (4). The available fluoroquinolones, including ciprofloxacin, are of limited interest in the treatment of infections by Enterococci, since they show moderate in vitro activity.
Which antibiotics cover enterococci?
Antibiotics with varying degrees of in vitro activity against enterococci include the penicillins (especially penicillin, ampicillin, and piperacillin), glycopeptides (vancomycin and teicoplanin), carbapenems (imipenem and meropenem), aminoglycosides, tetracyclines (tetracycline and doxycycline), quinolones (including …
Does Rocephin treat Enterococcus faecalis?
Ceftriaxone is also active against many strains of Pseudomonas aeruginosa. NOTE: Methicillin-resistant staphylococci are resistant to cephalosporins, including ceftriaxone. Most strains of Group D streptococci and enterococci, eg, Enterococcus (Streptococcus) faecalis, are resistant.
Does ceftriaxone cover Enterococcus faecalis?
Fernández-Hidalgo N, Almirante B, Gavaldà J, et al. Ampicillin plus ceftriaxone is as effective as ampicillin plus gentamicin for treating enterococcus faecalis infective endocarditis.
Does ciprofloxacin cover Enterococcus faecalis?
Conclusions. Ciprofloxacin is no longer a recommended therapy for E. faecalis from complicated UTI in men with risk factors. We suggest that ampicillin/sulbactam can be recommended as alternatives for treating ciprofloxacin-resistant E.
Will Rocephin cover Enterococcus?
Does levofloxacin cover Enterococcus?
In addition, levofloxacin is approved for the treatment of CBP caused by E. coli, E. faecalis, or Staphylococcus epidermidis.
Does doxycycline treat Enterococcus faecalis?
Conclusion: Enterococcus faecalis isolates were completely susceptible, in vitro, to amoxicillin, amoxicillin-clavulanic acid, vancomycin and moxifloxacin. Most isolates were susceptible to chloramphenicol, tetracycline, doxycycline or ciprofloxacin. Erythromycin and azithromycin were least effective.
Does Rocephin cover Enterococcus?
Does bactrim treat Enterococcus UTI?
Enterococci are intrinsically resistant to all Cephalosporins, Clindamycin, Bactrim. For polymicrobial infections, if Ampicillin-susceptible Enterococcus, Zosyn can also be used; if Ampicillin-susceptible E. faecalis, Meropenem can also be used.